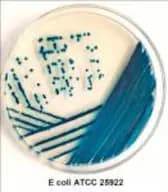
ChroMed E.coli Agar

Cell Culture Reagents
In this section, you will find a comprehensive selection of compounds and reagents essential for performing various cell cultures. These cell culture reagents are crucial for advancing research in microbiology and life sciences. They include media, supplements, growth factors, sera, and other additives necessary to create optimal conditions for cell growth, differentiation, and maintenance. Cell cultures are fundamental tools in studying cellular processes, drug development, genetic engineering, and disease mechanisms. At CymitQuimica, we offer high-quality reagents tailored to meet the specific requirements of different cell types and research applications, ensuring reliable and reproducible results in your cell culture experiments.
Found 1269 products of "Cell Culture Reagents"
Sort by
Purity (%)
0
100
|
0
|
50
|
90
|
95
|
100
ChroMed Bacillus Cereus Agar
Color and Shape:Light beige, Free flowing, homogeneous powder, Clear to slightly opalescent, Clear to very slightly opalescent, Red colouredSABHI Agar Base
Color and Shape:Light beige, Free flowing, homogeneous powder, , Clear to very slightly opalescentChocolate Agar Base
Color and Shape:Beige, Free flowing, homogeneous powder, Clear to very slightly opalescent, Clear to very slightly opalescent,Bile Salts Mixture BactoBio for bacteriology
Color and Shape:White to off white, Free flowing homogeneous powder, (1%) Clear and free from extraneous matter, (1%) Clear and free from extraneous matter, 1% aqueous solution is light straw colouredCzapek - Dox Agar
Color and Shape:Creamish white, Free flowing, homogeneous powder, Clear to very slightly opalescent with a slight precipitate, Clear to very slightly opalescent with a slight precipitate, Light amberPlate Count Agar (BIS Basis)
Color and Shape:Beige, Free flowing, homogeneous powder, Light to medium amber, Clear to slightly opalescentLitmus Milk (Litmus SM Broth)
Color and Shape:Light purple, Free flowing, homogeneous powder, Light purple, Opaque, milky solutionBolton Broth Base
Color and Shape:Light yellow to brownish yellow, Free flowing, homogeneous powder, Brownish yellow, Clear to slightly opalescentTerrific Broth (Tartoff-Hobbs Broth)
Color and Shape:Light beige, Free flowing, homogeneous powder, Light to medium amber, Clear without any precipitateMannitol Salt Agar (USP Basis)
Color and Shape:Light pink, Free flowing, homogeneous powder, Red, Clear to very slightly opalescentYersinia Selective Agar Base
Color and Shape:Light yellow to pink, Free flowing, homogeneous powder, Clear to slightly opalescent, OrangeBacitracin (BCT) ex. Bacillus Licheniformis for cell culture, Endotoxin (BET) 0.05EU/mg
CAS:Formula:C66H103N17O16SColor and Shape:White to off - white, Powder, ClearMolecular weight:1422.72Antibiotic Assay Medium No. 1 (Seed Agar)
Color and Shape:Light beige, Free flowing, homogeneous powder, Light to medium amber, Slightly opalescent gelNicotinic Acid (Pyridine-3-Carboxylic Acid) for cell culture, 99%, Endotoxin (BET) 0.05EU/mg
CAS:Formula:C6H5NO2Purity:min.99%Color and Shape:White to off-white, Crystalline powder, Clear, Colourless to pale yellowMolecular weight:123.11Differential Reinforced Clostridial Agar
Color and Shape:Light pink, Free flowing, homogenous powder, Light pink, Clear to slightly opalescent without any precipitateL-Glutamine for cell culture, 99%, Endotoxin (BET) 0.05EU/mg
CAS:Formula:C5H10N2O3Purity:min. 99%Color and Shape:White, Crystalline powder, Clear, ColourlessMolecular weight:146.15Sabouraud Dextrose Agar, Harmonized
Color and Shape:Light biege, Free flowing, homogeneous powder, Very slightly opalescent, Clear to very slightly opalescent, Light amberMarine Broth 2216 (Zobell)
Color and Shape:Cream, Free flowing, homogeneous powder, Slightly opalescent to opalescent, with presence of slight precipitate., Slightly opalescent to opalescent, with presence of slight precipitate. and few dark particles, Light amberAlgae Culture Agar
Color and Shape:Off white to cream, Free flowing, homogeneous powder, Slightly opalescent, Very slightly opalescent, Off white - Light amberTryptone Soya Broth (TSB) (Soyabean Casein Digest Medium, SCDM)
Color and Shape:Light cream, Free flowing powder, Clear without any precipitate, Clear, Clear without any precipitateCresyl Violet Acetate for cell culture, Endotoxin (BET) 0.5EU/mg
CAS:Formula:C18H15N3O3Purity:70%Color and Shape:Dark green to blackish, PowderMolecular weight:321.33Peptone Water BioVeg
Color and Shape:Beige, Free flowing, homogeneous powder, Clear without any precipitate, Clear without any precipitate, Light amberLuria Bertani Broth, Miller BioVeg
Color and Shape:Light yellow, Free flowing, homogeneous powder, Clear without any precipitate, Clear without any precipitate, Light to medium amberBaird-Parker Agar Base (BIS Basis)
Color and Shape:Light tan, Free flowing, homogeneous powder, Clear to very slightly opalescent, Yellow, OpaqueMacConkey Agar w/o C.V., NaCl w/ 0.5% Bile Salts
Color and Shape:Pinkish beige, Free flowing, homogeneous powder, Orange red, Clear to slightly opalescentCary-Blair Transport Medium Base (w/o Charcoal)
Color and Shape:Yellowish white, Free flowing, homogeneous powder, slightly opalescent may have a slight fine precipitate, Opalescent without significant precipitate, semi solid, Colourless to whitish greyViolet Red Bile Agar (BIS Basis)
Color and Shape:Biege, Free flowing, homogeneous powder, Reddish purple, Clear to slightly opalescentBG-11 Broth (Blue-Green Medium)
Color and Shape:Off white to cream, Free flowing homogeneous powder, Clear to slightly opalescent, may have presence of slight precipitate, Clear to slightly opalescent, may have presence of slight precipitate, ColourlessTryptose BactoBio for bacteriology
CAS:Color and Shape:Light yellow, Free flowing ,homogeneous powder, Light to medium amber, clearPhosphate Buffer, pH 8.0
Color and Shape:White to Off White, Free flowing, homogeneous powder, Clear without any precipitate, Clear without any precipitate, ColourlessHydrolysate BioVeg BactoBio for bacteriology
Color and Shape:Cream, Free flowing, homogeneous powder, Light amber, clearBeef Extract Agar (ex. Buffalo)
Color and Shape:Biege, Free flowing, homogeneous powder, Clear to very slightly opalescent, Clear to very slightly opalescent, Light to medium amberDiluting Fluid K
Color and Shape:Cream, Free flowing, homogeneous powder, Clear solution, Clear solution, Light yellow colouredToluidine Blue O for cell culture, 90%, Endotoxin (BET) 0.05EU/mg
CAS:Formula:C15H16ClN3SColor and Shape:Dark greenish, PowderMolecular weight:305.83Potassium Chloride for cell culture, 99.5%, Endotoxin (BET) 0.05EU/mg
CAS:Formula:KClPurity:min. 99.5%Color and Shape:White, Crystalline powder, Clear, ColourlessMolecular weight:74.55Enterococcus Confirmatory Broth
Color and Shape:Yellow with greenish tinge, Free flowing, homogeneous powder, Clear, Clear solution forms in tubes which acquires greenish tinge at the surface on standing, Light amberSoyabean Casein Digest Agar (SCDA) (Tryptone Soya Agar, TSA), Harmonized
Color and Shape:Cream to light yellow, Free flowing, homogeneous powder, Clear to slightly opalescent, Clear to very slightly opalescent, Cream to light yellowB.T.B. Lactose Agar
Color and Shape:Greenish yellow, Free flowing, homogeneous powder, Clear to slightly opalescent, Clear to slightly opalescent, Greenish blueBacillus Medium
Color and Shape:White to Cream, Free flowing, homogeneous powder, Clear solution with very slight precipitate, Clear solution with very slight precipitate, Cream to YellowShigella Broth Base
Color and Shape:Cream, Free flowing, homogeneous powder, Clear solution, Clear solution, Light amberL-Methionine for cell culture, 99%, Endotoxin (BET) 0.05EU/mg
CAS:Formula:C5H11NO2SPurity:min. 99%Color and Shape:White, Crystalline powder, Clear, ColourlessMolecular weight:149.21Arabinose Agar Base
Color and Shape:Light yellow to pink, Free flowing, homogeneous powder, Clear to slightly opalescent, Clear to very slightly opalescent, Red colouredBiochemical Test Kit - II (Pre-Weighed Media)
Color and Shape:Yellow, free flowing, homogeneous powder, Light amber, clear to slightly opalescent., Light green, free flowing, homogeneous powder, Bluish green, clear without any precipitate, Yellow, free flowing, homogeneous powder, Light amber, clear to slightly opaRhizobium Medium
Color and Shape:Cream to yellow, Free flowing, homogeneous powder, Yellow, Clear to slightly opalescentBacillus Differentiation Agar
Color and Shape:Light yellow to light green, Free flowing, homogeneous powder, Clear to slightly opalescent, Clear to very slightly opalescent, Light purpleLactose Peptone Broth
Color and Shape:Cream to greenish yellow, Free flowing, homogeneous powder, Dark reddish purple, Clear ,without any precipitateDextrose Broth
Color and Shape:Light beige, Free flowing, homogeneous powder, Clear, Clear, Light to medium amberM-TEC Agar
Color and Shape:Beige, Free flowing, homogeneous powder, Clear to very slightly opalescent, Dark purple w/red cast, Clear to very slightly opalescentNutrient Agar w/MUG
Color and Shape:Beige, Free flowing, homogeneous powder, Clear to very slightly opalescent, Clear to very slightly opalescent, Light amberDEV Tryptophan Broth
Color and Shape:Cream colour, Free flowing, homogeneous powder, Clear to slightly opalescent, Clear, Light amberSoyabean Casein Digest Medium (SCDM) (Tryptone Soya Broth, TSB), Harmonized
Color and Shape:Light biege, Clear, Clear, Light amberD-Maltose Monohydrate for cell culture, 92%, Endotoxin (BET) 0.05EU/mg
CAS:Formula:C12H22O11·H2OPurity:min. 92%Color and Shape:White, Crystalline powder, Clear, ColourlessMolecular weight:360.31Glycerol (Glycerine) Anhydrous for cell culture, 99.5%, Endotoxin (BET) 0.05EU/mg
CAS:Formula:C3H8O3Purity:min. 99.5%Color and Shape:Clear, Colourless, Liquid, max. 10Molecular weight:92.10Nicotinamide for cell culture, 99.5%, Endotoxin (BET) 0.05EU/mg
CAS:Formula:C6H6N2OPurity:min. 99.5%Color and Shape:White, Crystalline powderMolecular weight:122.13Dextrose for cell culture, Endotoxin (BET) 0.05EU/mg
CAS:Formula:C6H12O6Color and Shape:White, Crystalline powder, Clear, ColourlessMolecular weight:180.16Nitrate Agar
Color and Shape:Beige, Free flowing, homogeneous powder, Light amber, Clear to slightly opalescentNutrient Agar, pH 6.8
Color and Shape:Beige, Free flowing, homogeneous powder, Clear to very slightly opalescent, Clear to very slightly opalescent, BeigeLysozyme (3x cryst) ex.Egg white (Muramidase) for cell culture, 15000U/mg, Endotoxin (BET) 0.05EU/mg
CAS:Color and Shape:White, Crystalline powder, Clear, ColourlessN-Acetyl-DL-Tryptophan for cell culture, 99%, Endotoxin (BET) 0.05EU/mg
CAS:Formula:C13H14N2O3Purity:min.99%Color and Shape:White to off white, Crystalline powderMolecular weight:246.3DEV Nutrient Agar
Color and Shape:Beige, Free flowing, homogeneous powder, Light amber, Clear to slightly opalescent gelAscospore Agar
Color and Shape:Brownish yellow, Free flowing, homogeneous powder, Clear to slightly opalescent, Clear to slightly opalescent, Medium amberSelenite F Broth Base w/ Selenite (Twin Pack)
Color and Shape:Free flowing homogenous powder, Light yellow, Clear solution ,without any precipitateOxalacetic Acid for cell culture, 98%, Endotoxin (BET) 0.05EU/mg
CAS:Formula:C4H4O5Purity:min. 98%Color and Shape:White to off-white, Crystalline powderMolecular weight:132.07Nutrient Agar w/ 1% Peptone
Color and Shape:Beige, Free flowing, homogeneous powder, Light yellow, Clear to slightly opalescentChroMed TBX Agar (E.coli Agar Modified)
Color and Shape:Light biege, Free flowing, homogeneous powder, Clear to slightly opalescent, Clear to very slightly opalescent, Light amberSabouraud Dextrose Agar (USP, IP Basis)
Color and Shape:Light biege, Free flowing, homogeneous powder, Very slightly opalescent, Very slightly opalescent, Light amberBuffered Peptone Water w/ NaCl
Color and Shape:White to off-white, Free flowing, homogeneous powder, Clear, Clear without any precipitate, ColourlessEMB Agar
Color and Shape:Pinkish purple, Free flowing, homogeneous powder, Opalescent, with a uniform precipitate, Opalescent, with finely disperesed precipitate, Purple w/green orange castDiluting Fluid A
Color and Shape:Light cream, Free flowing, homogeneous powder, Clear solution without any precipitate, Light to medium amberM-Staphylococcus Broth
Color and Shape:Light cream colored, free flowing, homogeneous powder, Light to medium amber, clear solution without any precipitate, Clear solution without any precipitate, Light to medium amberL-Proline for cell culture, 99%, Endotoxin (BET) 1.0EU/mg
CAS:Formula:C5H9NO2Purity:min. 99%Color and Shape:White, Crystalline powder, Clear, ColourlessMolecular weight:115.13Vitamin B12 for cell culture, 97%, Endotoxin (BET) 0.05EU/mg
CAS:Formula:C63H88O14N14PCoPurity:min. 97%Color and Shape:Dark red, Crystalline powder, Clear, RedMolecular weight:1355.38Soyatone BactoBio for bacteriology
CAS:Color and Shape:Light to medium tan, Free,flowing homogeneous powder, Light to medium amber, clearMoeller Decarboxylase Broth Base (Decarboxylase Broth Base, Moeller)
Color and Shape:Greenish yellow, Free flowing, homogeneous powder, Purple, Clear without any precipitateSoyabean Casein Digest Medium (SCDM) (Tryptone Soya Broth, TSB)
Color and Shape:Light biege, Free flowing, homogeneous powder, Clear, Clear, Light amberChroMed ECC Agar
Color and Shape:Cream, Free flowing, homogeneous powder, Clear to slightly opalescent, Clear to very slightly opalescent, Light to medium amberYeast Extract for bacteriology
Color and Shape:Brownish yellow, free flowing, homogeneous powder, Medium amber to yellowish brown, clear to slightly opalescentPseudomonas Isolation Agar Base
Color and Shape:Free flowing, homogeneous powder, Very slightly opalescent, Very slightly opalescent, Light amberPyridoxine Hydrochloride (Vitamin B6) for cell culture, 99%, Endotoxin (BET) 1EU/mg
CAS:Formula:C8H11NO3·HClPurity:min. 99%Color and Shape:White to off-white, Crystalline powder, Clear, Colourless to pale yellowMolecular weight:205.64TCBS Agar
Color and Shape:Light tan w/greenish cast, Free flowing, homogeneous powder, Very slightly opalescent, Very slightly opalescent, Forest greenCampylobacter Agar Base
Color and Shape:Yellow, Free flowing, homogeneous powder, Clear to very slightly opalescent, Clear, Yellow, after addition of 5.0 -7.0% lysed blood forms reddish brown colored opalescent gel.Hektoen Enteric Agar
Color and Shape:Light beige, may have a slight green cast, Free flowing, homogeneous powder, Slightly opalescent., Slightly opalescent., Green with yellowish cast.Proteose Peptone BactoBio for bacteriology
CAS:Color and Shape:Free, flowing homogeneous powder, Light to medium amber, clearRiboflavin for cell culture, 98%, Endotoxin (BET) 0.05EU/mg
CAS:Formula:C17H20N4O6Purity:min. 98%Color and Shape:Orange yellow, Crystalline powder, Clear, OrangeMolecular weight:376.37Tryptophan Broth (Tryptophan Medium) BioVeg
Color and Shape:Cream, Free flowing, homogeneous powder, Clear without any precipitate, Clear without any precipitate, Cream to yellowPotato Infusion Powder (PI Powder) BactoBio for bacteriology
Color and Shape:Creamish yellow, Free flowing,spray dried powder., Completely soluble, (10.0% aq. solution ) ClearChroMed Salmonella Agar
Color and Shape:Light yellow, Free flowing, homogeneous powder, Slightly opalescent (before boiling), Very slightly opalescent (after boiling), Light amberLuria Bertani Agar, Miller BioVeg
Color and Shape:Light beige, Free flowing, homogeneous powder, Clear to very slightly opalescent, Clear to very slightly opalescent, Light amber to medium amberLauryl Sulfate Broth (Lauryl Tryptose Broth) (ISO, BIS Basis)
Color and Shape:Light yellow, Free flowing, homogeneous powder, Clear w/o any precipitate, Clear w/o any precipitate, Light yellowStarch Soluble Special (Cold Water Soluble) BactoBio for microbiology
CAS:Color and Shape:Amorphous powder., White to off-whiteColumbia C.N.A. Agar Base
Color and Shape:Light yellow, Free flowing, homogeneous powder, Clear to slightly opalescent, Opaque,Peptone Special BactoBio for bacteriology
Color and Shape:Tan, Free flowing, homogeneous powder, Light to medium amber, clearYeast Mannitol Broth
Color and Shape:Cream, Free flowing, homogeneous powder, Opalescent solution, Whitish buffElliker Broth (Lactobacilli Broth)
Color and Shape:Light beige, Free flowing, homogeneous powder, Clear without any precipitate, Clear without any precipitate, Light amberMagnesium Chloride Anhydrous for cell culture, 98%, Endotoxin (BET) 0.05EU/mg
CAS:Formula:MgCl2Purity:min. 98%Color and Shape:White, Deliquescent flakes ,may contain some dark particlesMolecular weight:95.21Sabouraud Dextrose Agar BioVeg
Color and Shape:Light beige, Free flowing, homogeneous powder, Very slightly opalescent, Very slightly opalescent, Light amberSoyabean Casein Digest Medium (SCDM) (Tryptone Soya Broth, TSB), Sterile (γ Irradiated)
Color and Shape:Light beige, Free flowing, homogeneous powder, Light amber, clear without any precipitate, Light amber, clear without any precipitateBuffered Peptone Water
Color and Shape:Cream to light tan, Free flowing, homogeneous powder, Clear without any precipitate, Clear without any precipitate, Light amberLactose Gelatin Medium (ISO Basis)
Color and Shape:Pink, Coarse, free flowing, homogeneous powder, Red, Clear to slightly opalescent, Red, Clear to very slightly opalescentSugar Free Agar (Count Agar Sugar-free)
Color and Shape:Beige, Free flowing, homogeneous powder, Medium amber, Clear to very slightly opalescentPlate Count Agar BioVeg
Color and Shape:Light cream, Free flowing, homogeneous powder, Clear to very slightly opalescent, Clear to very slightly opalescent, Light amberChroMed E.coli Agar
<p>Light yellow , free flowing, homogeneous powder. <br><br>Solubility: (before autoclaving) (36.57 gm/lit): Light yellow, clear to slightly opalescent.<br><br>Final pH at 25 deg C: 7.2 + 0.2 <br><br>Prepared medium appearance (after autoclaving): Light yellow , clear to slightly opalescent.<br><br>Directions:<br>1. Add 36.57 gm powder to 1.0 liter of distilled/deionized water and mix thoroughly.<br>2. Gently heat and bring to boiling.<br>3. Autoclave at 15 psi pressure at 121°C for 15 minutes.<br><br>* Cultural response: Inoculate and incubate at 440C for 18-24 hours with the following:<br>Organisms - Growth - Colony colour<br>Escherichia coli ATCC 25922 - Good - Blue-Green <br>Staphylococcus aureus ATCC 25923 - Inhibited <br><br>Storage:	2-8ºC<br><br><br><br><br><br><br><br><br><br><br><br>Associated Images<br><br><br> <br><br><br><br><br><br><br><br> <br> <br><br><br><br><br><br><br><br>Notes<br><br><br> <br><br><br><br><br><br><br><br> <br>A selection chromogenic medium used for the detection and enumeration of Escherichia Coli and coliform from food samples.</p>Color and Shape:Light yellow, Free flowing, homogeneous powder, Clear to slightly opalescent, Clear to very slightly opalescent, Light yellowBismuth Sulphite Agar (ISO Basis)
Color and Shape:Light beige to light green, Free flowing, homogeneous powder, Opaque with a flocculent precipitate, Opaque with a flocculent precipitate, Light grey-green to medium greenDairy samples Testing Kit (Pre-Weighed Media)
Color and Shape:Light cream, free flowing, homogeneous powder., Light amber, clear to very slightly opalescent, Pinkish biege, free flowing, homogeneous powder, Reddish purple, very slightly opalescent, Light yellow, free flowing, homogeneous powder., Light amber, very sMacConkey Agar w/o C.V. w/ 0.15% Bile Salts
Color and Shape:Pinkish beige, Free flowing, homogeneous powder, Orange red, Clear to very slightly opalescentDifferential Reinforced Clostridial Broth Base (ISO Basis)
Color and Shape:Yellow, Free flowing, homogeneous powder, Clear to very slightly opalescent., Clear without any precipitate, Light amberNutrient Gelatin
Color and Shape:Yellow, Free flowing, homogeneous powder, Light amber, Clear to slightly opalescentSS Agar, Modified (Salmonella-Shigella Agar, Modified)
Color and Shape:Pinkish yellow, Free flowing, homogeneous powder, Clear to very slightly opalescent, Clear to very slightly opalescent, Reddish orangeCandida Albicans Test Kit (Pre-Weighed Media)
Color and Shape:Light beige, Free flowing, homogeneous powder, Light amber, clear to very slightly opalescent, Cream, Free flowing, homogeneous powder, Light amber, clear without any precipitateLiver Hydrolysate BactoBio for bacteriology
Color and Shape:Brownish yellow to brown, Free .flowing homogeneous powder, Brownish yellow to brown, clearPhenol Red Sodium Salt (water soluble) for cell culture, 95%, Endotoxin (BET) 0.05EU/mg
CAS:Formula:C19H13NaO5Color and Shape:Red to dark red to brown, Powder, ClearMolecular weight:376.36r-Trypsin 1x w/ EDTA Soln in Phosphate Buffer for cell culture (AOF),150U/ml,Endotoxin (BET) 1EU/ml
Color and Shape:Clear, Colourless, LiquidDeoxycholate Lactose Agar
Color and Shape:Pinkish biege, Free flowing, homogeneous powder, Clear to slightly opalescent, Clear to very slightly opalescent, Reddish orangeL-Cysteine Hydrochloride Monohydrate for cell culture, 99%, Endotoxin (BET) 0.05EU/mg
CAS:Formula:C3H7NO2S·HCl·H2OPurity:min. 99%Color and Shape:White, Crystalline compound, Clear, ColourlessMolecular weight:175.63Lysine Decarboxylase Broth w/o Peptone (ISO Basis)
Color and Shape:Greenish yellow, Free flowing, homogeneous powder, Purple, Clear solution without any precipitateChloramphenicol cell culture, 99%, Endotoxin (BET) 0.2 EU/mg
CAS:Formula:C11H12Cl2N2O5Molecular weight:323.1ChroMed Candida Agar Base
Color and Shape:Beige, Free flowing, homogeneous powder, Light amber, Clear to slightly opalescentChroMed Listeria Ottaviani -Agosti Agar Base (ISO basis)
Color and Shape:Cream to yellow, Free flowing, homogeneous powder, Light amber, OpalescentCeftriaxone Disodium Salt Hemiheptahydrate (CFTZ) for cell culture, Endotoxin (BET) 0.2EU/mg
CAS:Formula:C18H16N8Na2O7S3·5H2OMolecular weight:661.60L-Leucine for cell culture, 99%, Endotoxin (BET) 1EU/mg
CAS:Formula:C6H13NO2Purity:min. 99%Color and Shape:White, Crystalline powder, Clear, ColourlessMolecular weight:131.17Peptone BioVeg Sterile for bacteriology (γ Irradiated)
Color and Shape:Light to medium tan, Light to medium amber,clearBryant and Burkey Agar
Color and Shape:Beige, Free flowing, homogeneous powder, Light amber, Clear to slightly opalescent solution with upper 10% or less medium pink on standingBacteroides Bile Esculin (BBE) Agar Base
Color and Shape:Cream to yellow, Free flowing, homogeneous powder, Clear to slightly opalescent, Clear to very slightly opalescent gel with bluish tinge, Medium amberAnaerobic Blood Agar Base
Color and Shape:Beige, Free flowing, homogenous powder, Clear to slightly opalescent, Cream to yellow, Clear to slightly opalescent gel,Bryant and Burkey Medium
Color and Shape:Beige, Free flowing, homogeneous powder, Light amber, Clear solution when hot, becomes pink-red upon cooling